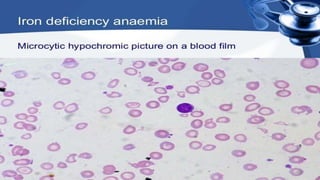
anemia.pptx

Embed presentation
Download to read offline











































The document appears to be a presentation by two individuals, Sikandar Baloch and Rizwan Munsif. No other contextual or content information is provided in the brief document, which only lists the names of the two presenters.